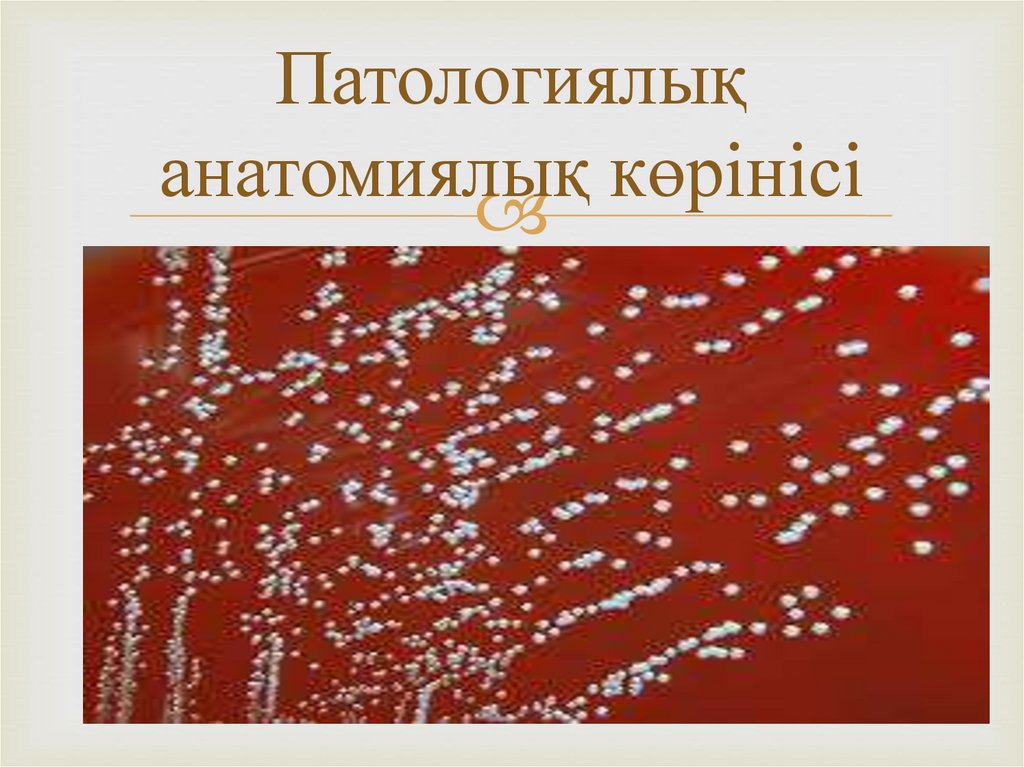

Similar presentations:
Брузеллез
1.
Орындаған Сұлтанбек АружанТексерген Айдар ағай
2.
БрузеллезБруцеллез (Brucellosis) – созылмалы өтетін, іш тастау, шуы түспеу,
эндометрит, орхит және жануарлардың жыныстық қабілетінің бұзылуы,
арқылы ерекшеленетін жұқпалы ауру. Бруцеллезді әр түрлі түлікте
Brucella туыстығына жататын 6 түрге бөлінетін микробтар қоздырады.
Кейбір түрлері өзара бірнеше биоварға (биотипке) бөлінеді. B.melitensis
қой мен ешкі үшін зардапты және адам бруцеллезінің негізгі
қоздырушысы, 3 биотипі бар. B.abortus сиыр, қодас, буйвол, бұғы,
марал, түйе және жылқы үшін зардапты, 9 биотипке бөлінеді. Кейбір
биотипінің адам үшін уыттылығы недәуір дәрежеде. B. suis шошқа, қоян,
солтүстік бұғысы үшін зардапты 4 биотипі бар, оның 1, 2 және 3-шісі
шошқада, 2-ші биотипі қоянда, 4-шісі бұғыда тоғышарлық етеді. B.
neotomae шөлейттегі егеуқұйрықта (Neotoma lepida) кездеседі. 1957ж.
АҚШ-та бөлініп алынған. Адам үшін зардаптылығы беймәлім. Биотипке
бөлінбейді. B.ovis қой үшін зардапты, қошқардың жұқпалы
эпидидимитінің қоздырушысы. Адам үшін зардаптылығы түбегейлі
анықталған жоқ. 1953 ж. Жаңа Зеландия мен Австралияда бөлініп
алынған, биотипке бөлінбейді. B.canis ит үшін зардапты, бұл жануардың
эпидидимиті мен іш тастаудың себепкері. 1968 ж АҚШ-та тазы иттерден
бөлініп алынған. Адамға зардаптылығы белгісіз. Биотиптерге бөлінбейді.
3.
.Бруцеллезге 60-тан артық үй және жабайы
жануарлар түрлері бейім. Әсіресе тез
шалдығатындары: сиыр, қой, ешкі, шошқа,
солтүстік бұғысы. Оларда бруцеллез індет
түрінде тарайды. Түйе, жылқы, марал, қодас,
буйвол сияқты жануарларда бәсеңдеу тарайды.
Ит, мысық, қоян, сайғақ, түлкілерде шектеулі
дәрежеде, болмаса спорадия ретінде кездеседі.
Бұл аурудың табиғи ошағы болмайдыИнфекция
қоздырушысының бастауына бруцеллезбен
ауырған малдар жатады, әсіресе олар клиникалық
белгілері айқын білінген кезде өте қауіпті. Ондай
жануарлар шаранамен, шумен, тастанды төлмен
және жыныс жолдарынан аққан сорамен ауру
қоздырушысын аса мол мөлшерде бөліп
шығарады. Қоздырушы микроб сонымен қатар
сүтпен, шәуетпен, нәжіспен және несеппен бірге
бөлінеді. Сиырдың желінінде бруцеллалар 7-9
жыл, ал қойда 2-3 жыл сақталып, оқтын-оқтын
сүтпен бөлініп тұрады. Бруцеллалармен
ластанған өнімдер және малдан алынған
шикізаттар, жануарларды күтуге арналған
жабдықтар, жемшөп, төсеніш, су, топырақ, малды
қарайтын адамдардың киімдері басты жұқтыру
факторлары болып табылады. Жас төлге
бруцеллез негізінен алиментарлық жолмен
енесінің сүті арқылы, ал сақа жануарларға
алиментарлық жолмен және шағылысқанда
жанасу арқылы жұғады.
4.
ның сарысуын жібереді. Бактериологиялықдиагноз үшін жағындыларды микроскоппен
қарап, ауру қоздырушысының өсіндісін алып,
теңіз тышқанына биологиялық сынама қояды.
Серологиялық реакциялар бруцеллезге малды
жаппай тексеру үшін кеңінен қолданылады.
Бұлардың ішіндегі ең танымал әдістер:
агглютинация реакциясы (АР), комплемент
байланыстыру реакциясы (КБР),
комплементті ұзақ байланыстыру реакциясы
(КҰБР), сонымен қатар роз бенгал сынамасы
(РБС). Соңғы кезде Қазақстанда ашылған
(Т.Сайдулдин, 1972) конглютининдеуші
кешенді байланыстыру реакциясы (ККБР)
немесе Сайдулдин реакциясы (СР) практикаға
енгізіле бастады. Жалпы індеттік жағдайды
бақылау үшін сүтпен қойылатын шығыршық
реакциясын (ШР) пайдалануға болады.
Аллергологиялық тексеру бруцеллездің соңғы
кезеңдерінде нәтижелі деп есептеледі. Бұл
үшін бруцеллин аллергені пайдаланылады.
Оны тері ішіне және тері астына (көздің
астыңғы қабағына) жібереді. Бірақ,
аллергиялық әдістің сезімталдығы
серологиялық реакциялардан төмен.
.
Белгілері :Дене
температурысының
көтерілуі (жі 3839°C)Тершеңдік,
әлсіздікБуын және
бұлшық еттердегі
ауырсыгулярБас
ауруыІштің ауырсынуы,
жүрек айнуы
5.
Жануарлардың барлықтүрінде брузеллез
буаздықтың екінші
жартысында басталатын
іш тастау сиыр 5-8
айлығында ешкілер 3-5
айлығында мегежіндер
кез келген уақытта итте
40-50 күнде болады
Жануарың жыныс
мүшелері емшегінің
үрпісі зақымдалады
.
6.
.бұл ауру кезінде ағзада байқалатын
құрылымдық өзгерістер. Бруцеллездің
әсері адамның әртүрлі ағзаларында
түрлі патологиялық өзгерістерге әкелуі
мүмкін. Ауру көбінесе ишкі
органдарға, буындарға, жүйке
жүйесіне, бауыр мен бүйрекке әсер
етеді. ### Бруцеллездің патологиялықанатомиялық белгілері: 1. **Бауыр мен
көкбауырдың өзгерістері**: **Гепатомегалия** (бауырдың үлкеюі)
мен **спленомегалия** (көкбауырдың
үлкеюи). - Бауырда және көкбауырда
ісіну, қантамырлардың кеңеюи, кейде
бұл органдарда абсцесса немесе
қабыну белгілері байқалады
Іштің тастаған малдың
қағанағы қабынады
оның бетіне фибрин
ірімтіктері жиналады
жатыры көк бауыры
ісінеді бауырында
абцесса болады еркек
малда іріңдеген өліетті
орхит , ұрғашы малда
мастит кездеседі және
киста болады
7.
Патологиялықанатомиялық көрінісі

medicine
medicine








